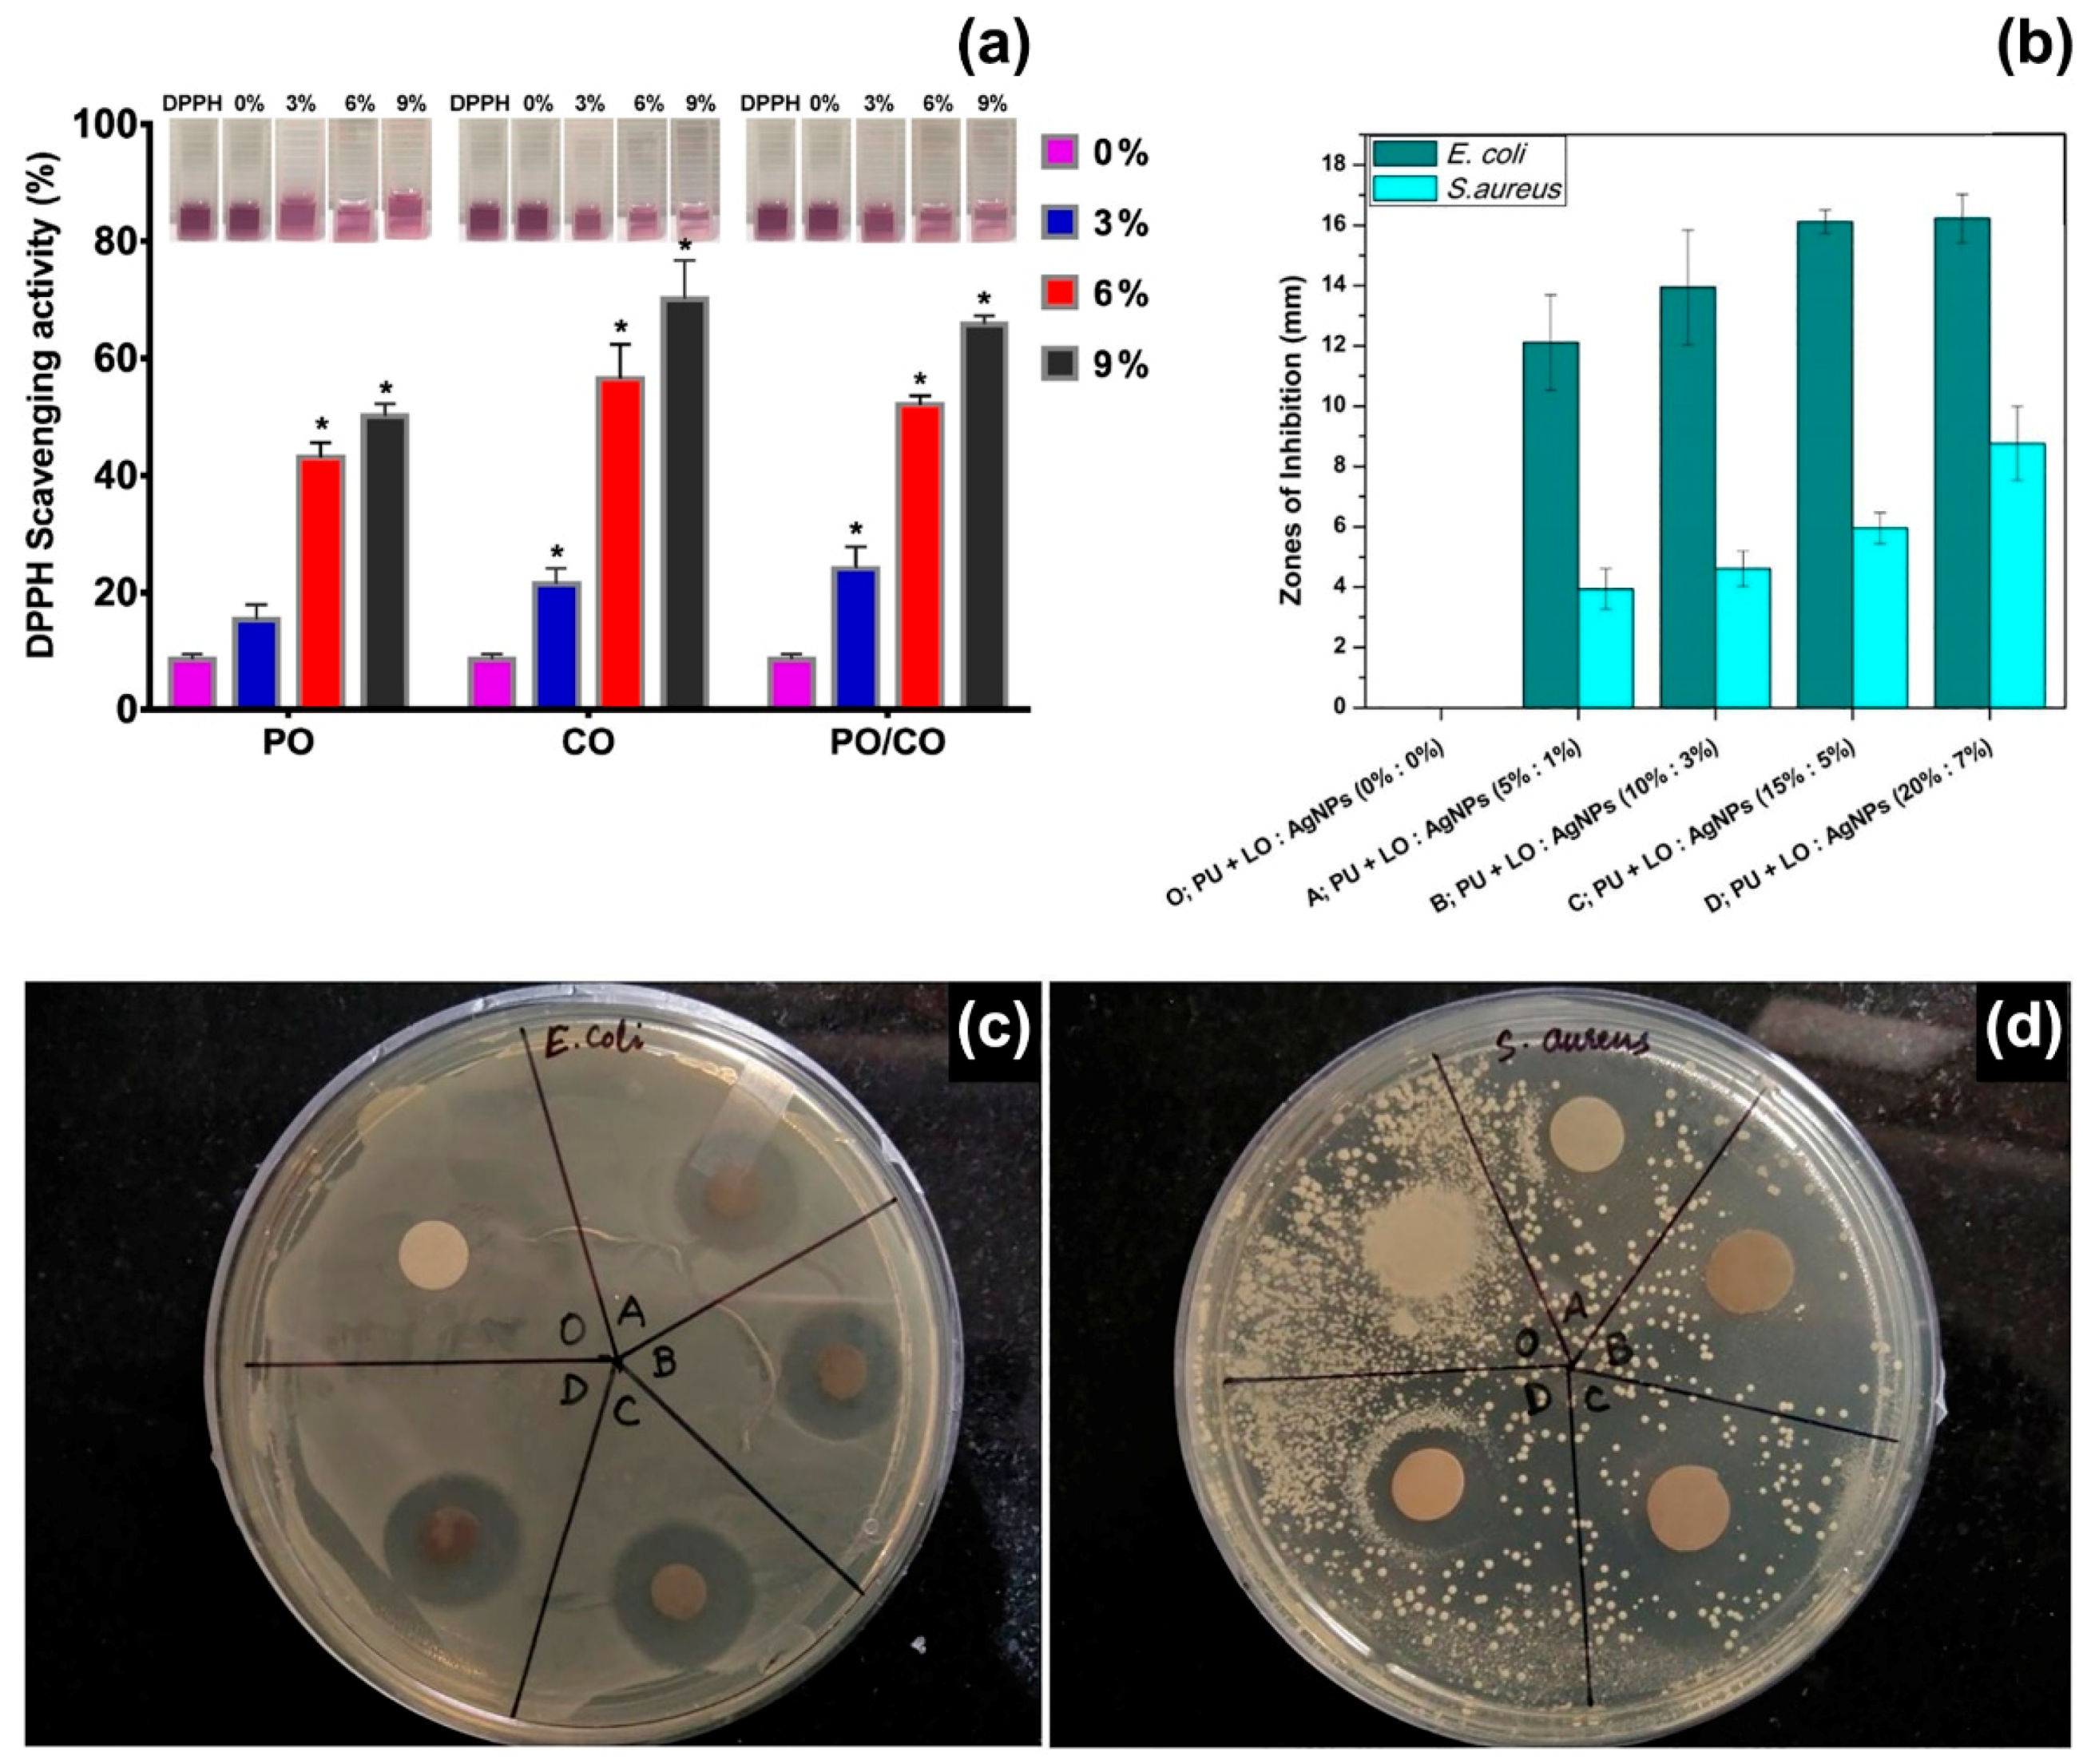
Polymers 12 00908 g003

Electrospinning of Essential Oils
Abstract
1. Introduction
2. Production of Polymeric Fibres by Solution Electrospinning
3. Electrospun Fibres Containing EOs and Their Applications
3.1. Cinnamon Essential Oil
3.2. Oregano Essential Oil
3.3. Peppermint Essential Oil
3.4. Clove Essential Oil
3.5. Thyme Essential Oil
3.6. Lavender Essential Oil
4. Conclusions
Conflicts of Interest
References
- Morgan, D.J.; Okeke, I.N.; Laxminarayan, R.; Perencevich, E.N.; Weisenberg, S. Non-prescription antimicrobial use worldwide: A systematic review. Lancet Infect. Dis. 2011, 11, 692–701. [Google Scholar] [CrossRef]
- Zhang, W.; Mele, E. Phase separation events induce the coexistence of distinct nanofeatures in electrospun fibres of poly (ethyl cyanoacrylate) and polycaprolactone. Mater. Today Commun. 2018, 16, 135–141. [Google Scholar] [CrossRef]
- Taiwo, A.M. A review of environmental and health effects of organochlorine pesticide residues in Africa. Chemosphere 2019, 220, 1126–1140. [Google Scholar] [CrossRef]
- Rani, M.; Shanker, U.; Jassal, V. Recent strategies for removal and degradation of persistent and toxic organochlorine pesticides using nanoparticles: A review. J. Environ. Manag. 2017, 190, 208–222. [Google Scholar] [CrossRef]
- Carvalho, F.P. Pesticides, environment, and food safety. Food Energy Secur. 2017, 6, 48–60. [Google Scholar] [CrossRef]
- Ambrosio, C.M.S.; de Alencar, S.M.; de Sousa, R.L.M.; Moreno, A.M.; Da Gloria, E.M. Antimicrobial activity of several essential oils on pathogenic and beneficial bacteria. Ind. Crops Prod. 2017, 97, 128–136. [Google Scholar] [CrossRef]
- Friedman, M. Antibiotic-resistant bacteria: Prevalence in food and inactivation by food-compatible compounds and plant extracts. J. Agric. Food Chem. 2015, 63, 3805–3822. [Google Scholar] [CrossRef]
- Walia, S.; Saha, S.; Tripathi, V.; Sharma, K.K. Phytochemical biopesticides: Some recent developments. Phytochem. Rev. 2017, 16, 989–1007. [Google Scholar] [CrossRef]
- Isman, M.B.; Miresmailli, S.; Machial, C. Commercial opportunities for pesticides based on plant essential oils in agriculture, industry and consumer products. Phytochem. Rev. 2011, 10, 197–204. [Google Scholar] [CrossRef]
- Rehman, R.; Hanif, M.A.; Mushtaq, Z.; Al-Sadi, A.M. Biosynthesis of essential oils in aromatic plants: A review. Food Rev. Int. 2016, 32, 117–160. [Google Scholar] [CrossRef]
- Bakkali, F.; Averbeck, S.; Averbeck, D.; Idaomar, M. Biological effects of essential oils—A review. Food Chem. Toxicol. 2008, 46, 446–475. [Google Scholar] [CrossRef] [PubMed]
- Sharifi-Rad, J.; Sureda, A.; Tenore, G.C.; Daglia, M.; Sharifi-Rad, M.; Valussi, M.; Tundis, R.; Sharifi-Rad, M.; Loizzo, M.R.; Ademiluyi, A.O.; et al. Biological activities of essential oils: From plant chemoecology to traditional healing systems. Molecules 2017, 22, 70. [Google Scholar] [CrossRef] [PubMed]
- Pichersky, E.; Gershenzon, J. The formation and function of plant volatiles: Perfumes for pollinator attraction and defense. Curr. Opin. Plant Biol. 2002, 5, 237–243. [Google Scholar] [CrossRef]
- Daviet, L.; Schalk, M. Biotechnology in plant essential oil production: Progress and perspective in metabolic engineering of the terpene pathway. Flavour Fragr. J. 2010, 25, 123–127. [Google Scholar] [CrossRef]
- Biswas, K.K.; Foster, A.J.; Aung, T.; Mahmoud, S.S. Essential oil production: Relationship with abundance of glandular trichomes in aerial surface of plants. Acta Physiol. Plant 2009, 31, 13–19. [Google Scholar] [CrossRef]
- Christianson, D.W. Structural and chemical biology of terpenoid cyclases. Chem. Rev. 2017, 117, 11570–11648. [Google Scholar] [CrossRef]
- Tetali, S.D. Terpenes and isoprenoids: A wealth of compounds for global use. Planta 2019, 249, 1–8. [Google Scholar] [CrossRef]
- McCreath, S.B.; Delgoda, R. Pharmacognosy: Fundamentals, Applications and Strategies; Academic Press: Cambridge, MA, USA, 2017. [Google Scholar]
- Deng, Y.; Lu, S. Biosynthesis and regulationn of phenylpropanoids in plants. Critical Rev. Plant Sci. 2017, 36, 257–290. [Google Scholar] [CrossRef]
- Merino, P.; Maiuolo, L.; Delso, I.; Algieri, V.; De Nino, A.; Tejero, T. Chemical approaches to inhibitors of isoprenoid biosynthesis: Targeting farnesyl and geranylgeranyl pyrophosphate synthases. RSC Adv. 2017, 7, 10947–10967. [Google Scholar] [CrossRef]
- Le Roy, J.; Huss, B.; Creach, A.; Hawkins, S.; Neutelings, G. Glycosylation is a major regulator of phenylpropanoid availability and biological activity in plants. Front. Plant Sci. 2016, 7, 735. [Google Scholar] [CrossRef]
- Yu, O.; Jez, J.M. Nature’s assembly line: Biosynthesis of simple phenylpropanoids and polyketides. Plant J. 2008, 54, 750–762. [Google Scholar] [CrossRef] [PubMed]
- Sangwan, N.S.; Farooqi, A.H.A.; Shabih, F.; Sangwan, R.S. Regulation of essential oil production in plants. Plant Growth Reg. 2001, 34, 3–21. [Google Scholar] [CrossRef]
- Maes, C.; Bouquillon, S.; Fauconnier, M.-L. Encapsulation of Essential Oils for the development of biosourced pesticides with controlled release: A review. Molecules 2019, 24, 2539. [Google Scholar] [CrossRef] [PubMed]
- Prakash, B.; Kujur, A.; Yadav, A.; Kumar, A.; Singh, P.P.; Dubey, N.K. Nanoencapsulation: An efficient technology to boost the antimicrobial potential of plant essential oils in food system. Food Control 2018, 89, 1–11. [Google Scholar] [CrossRef]
- Wadhwa, G.; Kumar, S.; Chhabra, L.; Mahant, S.; Rao, R. Essential oil–cyclodextrin complexes: An updated review. J. Incl. Phenom. Macrocycl. Chem. 2017, 89, 39–58. [Google Scholar] [CrossRef]
- Xue, J.; Wu, T.; Dai, Y.; Xia, Y. Electrospinning and electrospun nanofibers: Methods, materials, and applications. Chem. Rev. 2019, 119, 5298–5415. [Google Scholar] [CrossRef]
- Miguel, S.P.; Figueira, D.R.; Simões, D.; Ribeiro, M.P.; Coutinho, P.; Ferreira, P.; Correia, I.J. Electrospun polymeric nanofibres as wound dressings: A review. Coll. Surf. B Biointerfaces 2018, 169, 60–71. [Google Scholar] [CrossRef]
- Soares, R.M.D.; Siqueira, N.M.; Prabhakaram, M.P.; Ramakrishna, S. Electrospinning and electrospray of bio-based and natural polymers for biomaterials development. Mater. Sci. Eng. C 2018, 92, 969–982. [Google Scholar] [CrossRef]
- Han, J.; Xiong, L.; Jiang, X.; Yuan, X.; Zhao, Y.; Yang, D. Bio-functional electrospun nanomaterials: From topology design to biological applications. Prog. Polym. Sci. 2019, 91, 1–28. [Google Scholar] [CrossRef]
- Mele, E. Electrospinning of natural polymers for advanced wound care: Towards responsive and adaptive dressings. J. Mater. Chem. B 2016, 4, 4801–4812. [Google Scholar] [CrossRef]
- Thompson, C.J.; Chase, G.G.; Yarin, A.L.; Reneker, D.H. Effects of parameters on nanofiber diameter determined from electrospinning model. Polymer 2007, 48, 6913–6922. [Google Scholar] [CrossRef]
- Ghobeira, R.; Asadian, M.; Vercruysse, C.; Declercq, H.; De Geyter, N.; Morent, R. Wide-ranging diameter scale of random and highly aligned PCL fibers electrospun using controlled working parameters. Polymer 2018, 157, 19–31. [Google Scholar] [CrossRef]
- Rezabeigi, E.; Demarquette, N.R. Ultraporous membranes electrospun from nonsolvent-induced phase-separated ternary systems. Macromol. Rapid Commun. 2019, 40, 1800880. [Google Scholar] [CrossRef] [PubMed]
- Huang, C.; Thomas, N.L. Fabricating porous poly (lactic acid) fibres via electrospinning. Eur. Polym. J. 2018, 99, 464–476. [Google Scholar] [CrossRef]
- Kouparitsas, I.K.; Mele, E.; Ronca, S. Synthesis and electrospinning of polycaprolactone from an aluminium-based catalyst: Influence of the ancillary ligand and initiators on catalytic efficiency and fibre structure. Polymers 2019, 11, 677. [Google Scholar] [CrossRef] [PubMed]
- Denchai, A.; Tartarini, D.; Mele, E. Cellular response to surface morphology: Electrospinning and computational modelling. Front. Bioeng. Biotechnol. 2018, 6, 155. [Google Scholar] [CrossRef] [PubMed]
- Hajiali, H.; Contestabile, A.; Mele, E.; Athanassiou, A. Influence of topography of nanofibrous scaffolds on functionality of engineered neural tissue. J. Mater. Chem. B 2018, 6, 930–939. [Google Scholar] [CrossRef]
- Wen, P.; Zhu, D.-H.; Wu, H.; Zong, M.-H.; Jing, Y.-R.; Han, S.-Y. Encapsulation of cinnamon essential oil in electrospun nanofibrous film for active food packaging. Food Control 2016, 59, 366–376. [Google Scholar] [CrossRef]
- Feng, K.; Wen, P.; Yang, H.; Li, N.; Lou, W.Y.; Zong, M.H.; Wu, H. Enhancement of the antimicrobial activity of cinnamon essential oil-loaded electrospun nanofilm by the incorporation of lysozyme. RSC Adv. 2017, 7, 1572–1580. [Google Scholar] [CrossRef]
- Rafiq, M.; Hussain, T.; Abid, S.; Nazir, A.; Masood, R. Development of sodium alginate/PVA antibacterial nanofibers by the incorporation of essential oils. Mater. Res. Express 2018, 5, 035007. [Google Scholar] [CrossRef]
- Wen, P.; Zhu, D.-H.; Feng, K.; Liu, F.-J.; Lou, W.-Y.; Li, N.; Zong, M.-H.; Wu, H. Fabrication of electrospun polylactic acid nanofilm incorporating cinnamon essential oil/β-cyclodextrin inclusion complex for antimicrobial packaging. Food Chem. 2016, 196, 996–1004. [Google Scholar] [CrossRef] [PubMed]
- Lin, L.; Dai, Y.; Cui, H. Antibacterial poly (ethylene oxide) electrospun nanofibers containing cinnamon essential oil/beta-cyclodextrin proteoliposomes. Carbohydr. Polym. 2017, 178, 131–140. [Google Scholar] [CrossRef] [PubMed]
- Liakos, I.; Rizzello, L.; Hajiali, H.; Brunetti, V.; Carzino, R.; Pompa, P.P.; Athanassiou, A.; Mele, E. Fibrous wound dressings encapsulating essential oils as natural antimicrobial agents. J. Mater. Chem. B 2015, 3, 1583–1589. [Google Scholar] [CrossRef] [PubMed]
- Figueroa-Lopez, K.J.; Vicente, A.A.; Reis, M.A.; Torres-Giner, S.; Lagaron, J.M. Antimicrobial and antioxidant performance of various essential oils and natural extracts and their incorporation into biowaste derived poly (3-hydroxybutyrate-co-3-hydroxyvalerate) layers made from electrospun ultrathin fibers. Nanomaterials 2019, 9, 144. [Google Scholar] [CrossRef] [PubMed]
- Ardekani-Zadeh, A.H.; Hosseini, S.F. Electrospun essential oil-doped chitosan/poly (ε-caprolactone) hybrid nanofibrous mats for antimicrobial food biopackaging exploits. Carbohydr. Polym. 2019, 223, 115108. [Google Scholar] [CrossRef] [PubMed]
- Nadeem, M.; Bhutto, M.A.; Yu, F.; Xie, X.; El-Hamshary, H.; El-Faham, A.; Ibrahim, U.A.; Mo, X. Physico-chemical and biological evaluation of PLCL/SF nanofibers loaded with oregano essential oil. Pharmaceutics 2019, 11, 386. [Google Scholar] [CrossRef]
- Tyagi, A.K.; Malik, A. Antimicrobial potential and chemical composition of Mentha piperita oil in liquid and vapour phase against food spoiling microorganisms. Food Control 2011, 22, 1707–1714. [Google Scholar] [CrossRef]
- Unalan, I.; Slavik, B.; Buettner, A.; Goldmann, W.H.; Frank, G.; Boccaccini, A.R. Physical and antibacterial properties of peppermint essential oil loaded poly (ε-caprolactone) (PCL) electrospun fiber mats for wound healing. Front. Bioeng. Biotech. 2019, 7, 346. [Google Scholar] [CrossRef]
- Tang, Y.; Zhou, Y.; Lan, X.; Huang, D.; Luo, T.; Ji, J.; Mafang, Z.; Miao, X.; Wang, H.; Wang, W. Electrospun gelatin nanofibers encapsulated with peppermint and chamomile essential oils as potential edible packaging. J. Agric. Food Chem. 2019, 67, 2227–2234. [Google Scholar] [CrossRef]
- Jaganathan, S.K.; Mani, M.P.; Khudzari, A.Z.M. Electrospun combination of peppermint oil and copper sulphate with conducive physico-chemical properties for wound dressing applications. Polymers 2019, 11, 586. [Google Scholar] [CrossRef]
- Bharathi, B.S.; Stalin, T. Cerium oxide and peppermint oil loaded polyethylene oxide/graphene oxide electrospun nanofibrous mats as antibacterial wound dressings. Mater. Today Commun. 2019, 21, 100664. [Google Scholar] [CrossRef]
- Sahal, G.; Nasseri, B.; Ebrahimi, A.; Bilkay, I.S. Electrospun essential oil-polycaprolactone nanofibers as antibiofilm surfaces against clinical Candida tropicalis isolates. Biotechnol. Lett. 2019, 41, 511–522. [Google Scholar] [CrossRef] [PubMed]
- Cui, H.; Bai, M.; Rashed, M.M.; Lin, L. The antibacterial activity of clove oil/chitosan nanoparticles embedded gelatin nanofibers against Escherichia coli O157: H7 biofilms on cucumber. Int. J. Food Microbiol. 2018, 266, 69–78. [Google Scholar] [CrossRef] [PubMed]
- Unalan, I.; Endlein, S.J.; Slavik, B.; Buettner, A.; Goldmann, W.H.; Detsch, R.; Boccaccini, A.R. Evaluation of electrospun poly (ε-caprolactone)/gelatin nanofiber mats containing clove essential oil for antibacterial wound dressing. Pharmaceutics 2019, 11, 570. [Google Scholar] [CrossRef]
- Yadav, R.; Balasubramanian, K. Polyacrylonitrile/Syzygium aromaticum hierarchical hydrophilic nanocomposite as a carrier for antibacterial drug delivery systems. RSC Adv. 2014, 5, 3291–3298. [Google Scholar] [CrossRef]
- Tonglairoum, P.; Ngawhirunpat, T.; Rojanarata, T.; Kaomongkolgit, R.; Opanasopit, P. Fabrication and evaluation of nanostructured herbal oil/hydroxypropyl-β-cyclodextrin/polyvinylpyrrolidone mats for denture stomatitis prevention and treatment. AAPS PharmSciTech 2016, 17, 1441–1449. [Google Scholar] [CrossRef]
- Liu, J.X.; Dong, W.H.; Mou, X.J.; Liu, G.S.; Huang, X.W.; Yan, X.; Zhou, C.F.; Jiang, S.; Long, Y.Z. In situ electrospun zein/thyme essential oil-based membranes as an effective antibacterial wound dressing. ACS Appl. Bio Mater. 2020, 3, 302–307. [Google Scholar] [CrossRef]
- Dadras Chomachayi, M.; Solouk, A.; Akbari, S.; Sadeghi, D.; Mirahmadi, F.; Mirzadeh, H. Electrospun nanofibers comprising of silk fibroin/gelatin for drug delivery applications: Thyme essential oil and doxycycline monohydrate release study. J. Biomed. Mater. Res. Part A 2018, 106, 1092–1103. [Google Scholar] [CrossRef]
- Lin, L.; Liao, X.; Cui, H. Cold plasma treated thyme essential oil/silk fibroin nanofibers against Salmonella Typhimurium in poultry meat. Food Packag. Shelf Life 2019, 21, 100337. [Google Scholar] [CrossRef]
- Çallıoğlu, F.C.; Güler, H.K.; Çetin, E.S. Emulsion electrospinning of bicomponent poly (vinyl pyrrolidone)/gelatin nanofibers with thyme essential oil. Mater. Res. Express 2019, 6, 125013. [Google Scholar] [CrossRef]
- Hajiali, H.; Summa, M.; Russo, D.; Armirotti, A.; Brunetti, V.; Bertorelli, R.; Athanassiou, A.; Mele, E. Alginate-lavender nanofibers with antibacterial and anti-inflammatory activity to effectively promote burn healing. J. Mater. Chem. B 2016, 4, 1686–1695. [Google Scholar] [CrossRef] [PubMed]
- Sofi, H.S.; Akram, T.; Tamboli, A.H.; Majeed, A.; Shabir, N.; Sheikh, F.A. Novel lavender oil and silver nanoparticles simultaneously loaded onto polyurethane nanofibers for wound-healing applications. Int. J. Pharm. 2019, 569, 118590. [Google Scholar] [CrossRef] [PubMed]
- Balasubramanian, K.; Kodam, K.M. Encapsulation of therapeutic lavender oil in an electrolyte assisted polyacrylonitrile nanofibres for antibacterial applications. RSC Adv. 2014, 4, 54892–54901. [Google Scholar] [CrossRef]
- Antunes, M.D.; da Silva Dannenberg, G.; Fiorentini, Â.M.; Pinto, V.Z.; Lim, L.T.; da Rosa Zavareze, E.; Dias, A.R.G. Antimicrobial electrospun ultrafine fibers from zein containing eucalyptus essential oil/cyclodextrin inclusion complex. Int. J. Biolog. Macromol. 2017, 104, 874–882. [Google Scholar] [CrossRef] [PubMed]
- Da Silva, F.T.; da Cunha, K.F.; Fonseca, L.M.; Antunes, M.D.; El Halal, S.L.M.; Fiorentini, Â.M.; da Rosa Zavareze, E.; Dias, A.R.G. Action of ginger essential oil (Zingiber officinale) encapsulated in proteins ultrafine fibers on the antimicrobial control in situ. Int. J. Biolog. Macromol. 2018, 118, 107–115. [Google Scholar] [CrossRef]
- Cui, H.; Bai, M.; Lin, L. Plasma-treated poly (ethylene oxide) nanofibers containing tea tree oil/beta-cyclodextrin inclusion complex for antibacterial packaging. Carbohydr. Polym. 2018, 179, 360–369. [Google Scholar] [CrossRef]
- Zhang, W.; Huang, C.; Kusmartseva, O.; Thomas, N.L.; Mele, E. Electrospinning of polylactic acid fibres containing tea tree and manuka oil. React. Funct. Polym. 2017, 117, 106–111. [Google Scholar] [CrossRef]
- Wang, P.; Mele, E. Effect of antibacterial plant extracts on the morphology of electrospun poly (lactic acid) fibres. Materials 2018, 11, 923. [Google Scholar] [CrossRef]
- D’Agostino, M.; Tesse, N.; Frippiat, J.P.; Machouart, M.; Debourgogne, A. Essential oils and their natural active compounds presenting antifungal properties. Molecules 2019, 24, 3713. [Google Scholar] [CrossRef]
- Zhang, Y.; Liu, X.; Wang, Y.; Jiang, P.; Quek, S. Antibacterial activity and mechanism of cinnamon essential oil against Escherichia coli and Staphylococcus aureus. Food Control 2016, 59, 282–289. [Google Scholar] [CrossRef]
- Huang, D.F.; Xu, J.G.; Liu, J.X.; Zhang, H.; Hu, Q.P. Chemical constituents, antibacterial activity and mechanism of action of the essential oil from Cinnamomum cassia bark against four food-related bacteria. Microbiology 2014, 83, 357–365. [Google Scholar] [CrossRef]
- Wang, Y.; Zhang, Y.; Shi, Y.Q.; Pan, X.H.; Lu, Y.H.; Cao, P. Antibacterial effects of cinnamon (Cinnamomum zeylanicum) bark essential oil on Porphyromonas gingivalis. Microb. Pathogen. 2018, 116, 26–32. [Google Scholar] [CrossRef]
- Goni, P.; López, P.; Sánchez, C.; Gómez-Lus, R.; Becerril, R.; Nerín, C. Antimicrobial activity in the vapour phase of a combination of cinnamon and clove essential oils. Food Chem. 2009, 116, 982–989. [Google Scholar] [CrossRef]
- Kfoury, M.; Landy, D.; Fourmentin, S. Characterization of cyclodextrin/volatile inclusion complexes: A Review. Molecules 2018, 23, 1204. [Google Scholar] [CrossRef] [PubMed]
- Topuz, F.; Uyar, T. Electrospinning of cyclodextrin functional nanofibers for drug delivery applications. Pharmaceutics 2019, 11, 6. [Google Scholar] [CrossRef]
- Han, J.-W.; Ruiz-Garcia, L.; Qian, J.-P.; Yang, X.-T. Food packaging: A comprehensive review and future trends. Compreh. Rev. Food Sci. Food Saf. 2018, 17, 860–877. [Google Scholar] [CrossRef]
- Majed, R.; Faille, C.; Kallassy, M.; Gohar, M. Bacillus cereus biofilms—Same, only different. Front. Microbiol. 2016, 7, 1054. [Google Scholar] [CrossRef]
- Cui, H.; Zhang, C.; Li, C.; Lin, L. Antibacterial mechanism of oregano essential oil. Ind. Crops Prod. 2019, 139, 111498. [Google Scholar] [CrossRef]
- Pezzani, R.; Vitalini, S.; Iriti, M. Bioactivities of Origanum vulgare L.: An update. Phytochem. Rev. 2017, 16, 1253–1268. [Google Scholar] [CrossRef]
- Lv, F.; Liang, H.; Yuan, Q.; Li, C. In vitro antimicrobial effects and mechanism of action of selected plant essential oil combinations against four food-related microorganisms. Food Res. Int. 2011, 44, 3057–3064. [Google Scholar] [CrossRef]
- Lu, M.; Dai, T.; Murray, C.K.; Wu, M.X. Bactericidal property of oregano oil against multidrug-resistant clinical isolates. Front. Microbiol. 2018, 9, 2329. [Google Scholar] [CrossRef] [PubMed]
- Soković, M.; Vukojević, J.; Marin, P.; Brkić, D.; Vajs, V.; Van Griensven, L. Chemical composition of essential oils of thymus and mentha species and their antifungal activities. Molecules 2009, 14, 238–249. [Google Scholar] [CrossRef] [PubMed]
- İşcan, G.; Kïrïmer, N.; Kürkcüoǧlu, M.; Başer, H.C.; Demirci, F. Antimicrobial screening of Mentha piperita essential oils. J. Agric. Food Chem. 2002, 50, 3943–3946. [Google Scholar] [CrossRef] [PubMed]
- Sun, Z.; Wang, H.; Wang, J.; Zhou, L.; Yang, P. Chemical composition and anti-inflammatory, cytotoxic and antioxidant activities of essential oil from leaves of Mentha piperita grown in China. PloS ONE 2014, 9, e114767. [Google Scholar] [CrossRef]
- Sizova, N.V. Composition and antioxidant activity of essential oils containing azulene derivatives. Pharm. Chem. J. 2012, 46, 369–371. [Google Scholar] [CrossRef]
- Fahimirad, S.; Ajalloueian, F. Naturally-derived electrospun wound dressings for target delivery of bio-active agents. Int. J. Pharm. 2019, 566, 307–328. [Google Scholar] [CrossRef]
- Miyazawa, M.; Hisama, M. Antimutagenic activity of phenylpropanoids from clove (Syzygium aromaticum). J. Agric. Food Chem. 2003, 51, 6413–6422. [Google Scholar] [CrossRef]
- Fichi, G.; Flamini, G.; Giovanelli, F.; Otranto, D.; Perrucci, S. Efficacy of an essential oil of Eugenia caryophyllata against Psoroptes cuniculi. Exp. Parasitol. 2007, 115, 168–172. [Google Scholar] [CrossRef]
- Chaieb, K.; Hajlaoui, H.; Zmantar, T.; Kahla-Nakbi, A.B.; Rouabhia, M.; Mahdouani, K.; Bakhrouf, A. The chemical composition and biological activity of clove essential oil, Eugenia caryophyllata (Syzigium aromaticum L. Myrtaceae): A short review. Phytoth. Res. 2007, 21, 501–506. [Google Scholar] [CrossRef]
- Moon, S.E.; Kim, H.Y.; Cha, J.D. Synergistic effect between clove oil and its major compounds and antibiotics against oral bacteria. Arch. Oral Biol. 2011, 56, 907–916. [Google Scholar] [CrossRef]
- Khalil, A.A.; ur Rahman, U.; Khan, M.R.; Sahar, A.; Mehmood, T.; Khan, M. Essential oil eugenol: Sources, extraction techniques and nutraceutical perspectives. RSC Adv. 2017, 7, 32669–32681. [Google Scholar] [CrossRef]
- Xu, J.G.; Liu, T.; Hu, Q.P.; Cao, X.M. Chemical composition, antibacterial properties and mechanism of action of essential oil from clove buds against Staphylococcus aureus. Molecules 2016, 21, 1194. [Google Scholar] [CrossRef] [PubMed]
- Prashar, A.; Locke, I.C.; Evans, C.S. Cytotoxicity of clove (Syzygium aromaticum) oil and its major components to human skin cells. Cell Prolif. 2006, 39, 241–248. [Google Scholar] [CrossRef] [PubMed]
- Slameňová, D.; Horváthová, E.; Wsólová, L.; Šramková, M.; Navarová, J. Investigation of anti-oxidative, cytotoxic, DNA-damaging and DNA-protective effects of plant volatiles eugenol and borneol in human-derived HepG2, Caco-2 and VH10 cell lines. Mutat. Res. Genet. Toxicol. Environ. Mutagen. 2009, 677, 46–52. [Google Scholar] [CrossRef] [PubMed]
- Li, Z.; Zhou, P.; Zhou, F.; Zhao, Y.; Ren, L.; Yuan, X. Antimicrobial eugenol-loaded electrospun membranes of poly (ε-caprolactone)/gelatin incorporated with REDV for vascular graft applications. Coll. Surf. B Biointerfaces 2018, 162, 335–344. [Google Scholar] [CrossRef]
- Nabavi, S.M.; Marchese, A.; Izadi, M.; Curti, V.; Daglia, M.; Nabavi, S.F. Plants belonging to the genus Thymus as antibacterial agents: From farm to pharmacy. Food Chem. 2015, 173, 339–347. [Google Scholar] [CrossRef]
- Tariq, S.; Wani, S.; Rasool, W.; Bhat, M.A.; Prabhakar, A.; Shalla, A.H.; Rather, M.A. A comprehensive review of the antibacterial, antifungal and antiviral potential of essential oils and their chemical constituents against drug-resistant microbial pathogens. Microb. Pathogen. 2019, 134, 103580. [Google Scholar] [CrossRef]
- Pirbalouti, A.G.; Hashemi, M.; Ghahfarokhi, F.T. Essential oil and chemical compositions of wild and cultivated Thymus daenensis Celak and Thymus vulgaris L. Ind. Crops Prod. 2013, 48, 43–48. [Google Scholar] [CrossRef]
- Rota, M.C.; Herrera, A.; Martínez, R.M.; Sotomayor, J.A.; Jordán, M.J. Antimicrobial activity and chemical composition of Thymus vulgaris, Thymus zygis and Thymus hyemalis essential oils. Food Control 2008, 19, 681–687. [Google Scholar] [CrossRef]
- Aprotosoaie, A.C.; Gille, E.; Trifan, A.; Luca, V.S.; Miron, A. Essential oils of Lavandula genus: A systematic review of their chemistry. Phytochem. Rev. 2017, 16, 761–799. [Google Scholar] [CrossRef]
- Dobetsberger, C.; Buchbauer, G. Actions of essential oils on the central nervous system: An updated review. Flavour Fragr. J. 2011, 26, 300–316. [Google Scholar] [CrossRef]
- Cavanagh, H.M.A.; Wilkinson, J.M. Biological activities of lavender essential oil. Phytotherapy Res. 2002, 16, 301–308. [Google Scholar] [CrossRef] [PubMed]
- Nikolić, M.; Jovanović, K.K.; Marković, T.; Marković, D.; Gligorijević, N.; Radulović, S.; Soković, M. Chemical composition, antimicrobial, and cytotoxic properties of five Lamiaceae essential oils. Ind. Crops Prod. 2014, 61, 225–232. [Google Scholar] [CrossRef]
- Prashar, A.; Locke, I.C.; Evans, C.S. Cytotoxicity of lavender oil and its major components to human skin cells. Cell Prolif. 2004, 37, 221–229. [Google Scholar] [CrossRef] [PubMed]
- Gavanji, S.; Mohammadi, E.; Larki, B.; Bakhtari, A. Antimicrobial and cytotoxic evaluation of some herbal essential oils in comparison with common antibiotics in bioassay condition. Integr. Med. Res. 2014, 3, 142–152. [Google Scholar] [CrossRef]

© 2020 by the author. Licensee MDPI, Basel, Switzerland. This article is an open access article distributed under the terms and conditions of the Creative Commons Attribution (CC BY) license (http://creativecommons.org/licenses/by/4.0/).
Share and Cite
Mele, E. Electrospinning of Essential Oils. Polymers 2020, 12, 908. https://doi.org/10.3390/polym12040908
Mele E. Electrospinning of Essential Oils. Polymers. 2020; 12(4):908. https://doi.org/10.3390/polym12040908
Chicago/Turabian StyleMele, Elisa. 2020. "Electrospinning of Essential Oils" Polymers 12, no. 4: 908. https://doi.org/10.3390/polym12040908
APA StyleMele, E. (2020). Electrospinning of Essential Oils. Polymers, 12(4), 908. https://doi.org/10.3390/polym12040908
